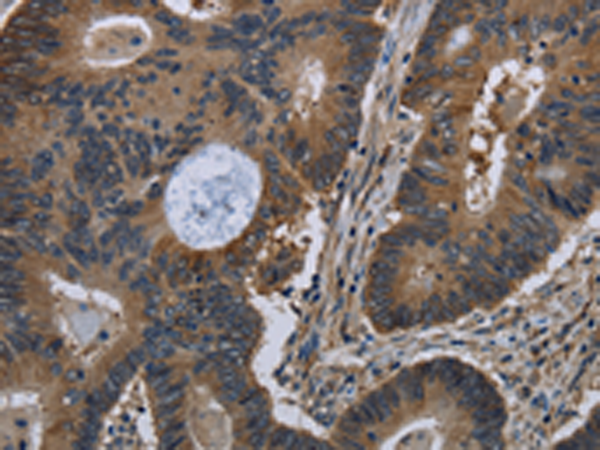

中文名稱: 兔抗TSC22D3多克隆抗體
|
Background: |
The protein encoded by this gene shares significant sequence identity with the murine TSC-22 and Drosophila shs, both of which are leucine zipper proteins, that function as transcriptional regulators. The expression of this gene is stimulated by glucocorticoids and interleukin 10, and it appears to play a key role in the anti-inflammatory and immunosuppressive effects of this steroid and chemokine. Transcript variants encoding different isoforms have been identified for this gene. |
|
Applications: |
ELISA, IHC |
|
Name of antibody: |
TSC22D3 |
|
Immunogen: |
Fusion protein of human TSC22D3 |
|
Full name: |
TSC22 domain family, member 3 |
|
Synonyms: |
DIP; GILZ; hDIP; DSIPI; TSC-22R |
|
SwissProt: |
Q99576 |
|
ELISA Recommended dilution: |
2000-5000 |
|
IHC positive control: |
Human colon cancer and Human liver cancer |
|
IHC Recommend dilution: |
50-200 |
購物車
幫助
021-54845833/15800441009
